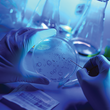

Faculty Research
Our multidisciplinary faculty leverages the collaborative culture at BCM and the resources of the College and the Texas Medical Center to conduct cutting-edge research across diverse areas of focus in cancer and cell biology. Explore the research foci below to find faculty whose interests align with yours.
"If there is something you are interested in that has anything to do with biomedical sciences, there is someone here who does it or knows somebody who does. There is an astounding number of labs here which offers a lot of opportunity for collaboration." - Rachel Curry, Ph.D. Student
Cancer and Cell Biology Research Resources
As you begin your career in research it is impossible to predict where your investigations will lead. Therefore, it is essential to have access to diverse resources, including equipment but also experienced individuals available to help you identify the resources you need and master their use.
Special facilities important to research in cancer and cell biology include core laboratories for recombinant DNA research, histopathology, multiple tissue culture facilities, laser scanning confocal microscopy, high throughput fluorescent microscopy, deconvolution microscopy, transmission and scanning electron microscopy, mass spectrometry, computer facilities for structural/computational biology, baculovirus/monoclonal antibody production, large and small scale immunoisolation of protein complexes and viral vector production.
A modern transgenic mouse facility provides state-of-the-art technology to generate transgenic and knockout mutant mouse models that are used by many faculty and students. The high level of cooperation among the various departments and centers at BCM and the institutions of the Houston scientific community provide access to additional facilities.
Dan L Duncan Comprehensive Cancer Center
The shared resources of the Dan L Duncan Comprehensive Cancer Center provide extensive services essential to cancer research.

Advanced Technology Cores
Advanced technology core laboratories provide state-of-the-art instrumentation and technologies as well as consultation on experimental design, data analysis and training. Through the cores, you will not only gain access to tools and techniques that support your research, you will also receive training and mentorship in how to leverage these tools to develop innovative approaches to scientific challenges.

As a member of the Texas Medical Center, Baylor College of Medicine leverages the resources of the world’s largest medical complex. In addition to supporting collaborations with the many hospitals, schools and research institutes in the TMC, the Center also facilitates state of the art research through specialized resources, including the TMC Innovation Institute, the TMC Library, and TCM Health Policy Institute.

See all the resources available to you as a student in the Cancer and Cell Biology Program at Baylor College of Medicine.
 Credit
Credit
Dr. Margaret Goodell and M.D./Ph.D. student, Joanne Ino Hsu, discuss their findings that showed cytotoxic chemotherapies put patients at risk for future hematopoietic malignancies.
Dr. Xiang Zhang explains how his paper published in Nature could change the way researchers look at anti-cancer therapies.
Estrogen hormones regulate gene expression. They achieve this by first binding to estrogen receptor in the cell nucleus, which triggers the recruitment of different molecules called coactivators in a specific order. In a study published in Molecular Cell, a team of researchers at Baylor College of Medicine, The University of Texas MD Anderson Cancer Center and The University of Texas Health Science Center at Houston shows that the sequential recruitment of coactivators is not simply adding molecules to the complex, it results in dynamic specific structural and functional changes that are necessary for effective regulation of gene expression.








